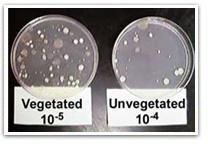
Tobramycin Injection

100 - 300 / Piece














Be first to Rate
Rate ThisOpening Hours